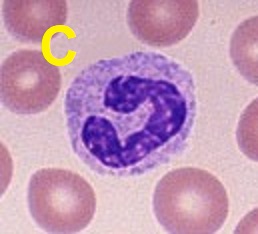

Check-In for Lab 6
DUE no later than 12 noon on Thursday July 28 (Summer Session II)
or 8 p.m. on Friday October 14 (Fall semester).
|
In order to show that you studied this lab carefully, please email me at
eminkoff
with your NAME and the answers to these 5 questions: (No need to repeat the questions; the answers alone will do.)
|